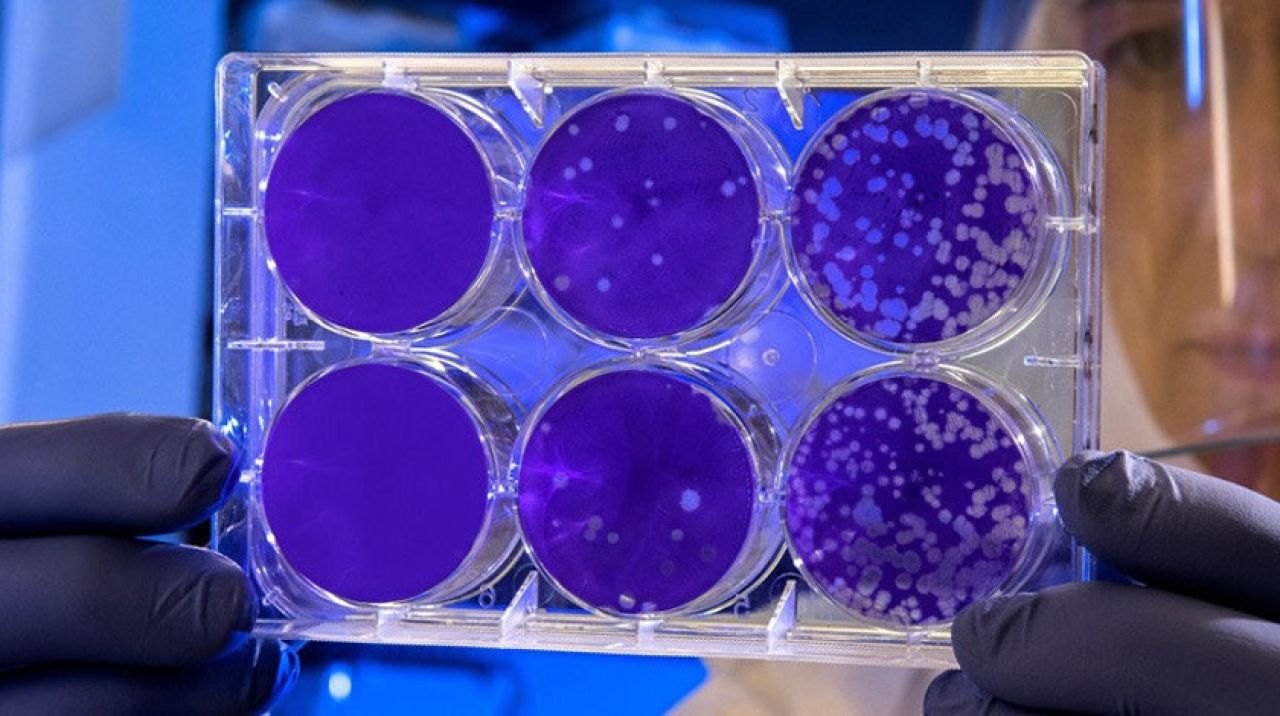

İlk olarak Çin'in Vuhan kentinde ortaya çıkan ve dünyada 2,2 milyondan fazla insanı etkileyen yeni tip koronavirüs (Kovid-19) hastalığının herkes tarafından en bilinen belirtileri solunum sıkıntısı, ateş ve öksürük olsa da yeni yayınlanan raporlar hastalığın nörolojik etkilerinin de olduğunu ortaya koyuyor.
Geçtiğimiz hafta Amerikan Tabipler Birliği Dergisi'nde yayınlanan bir çalışma, 214 Çinli hastanın yüzde 36,4'ünde koku almada bozukluğu, sinir ağrısı, nöbet ve felç gibi nörolojik semptomlar görüldüğünü ortaya koydu.
New York'taki hastanelere başvuran Covid-19 hastaları arasında nerede olduklarını veya hangi yıl olduğunu bilemeyen hastalar dikkat çekiyor.
AKCİĞER PROBLEMİNDEN BAĞIMSIZ
Euronews'in haberine göre bu durum, kanlarındaki düşük oksijen seviyelerine bağlı olsa da bazı hastalarda bu gibi kafa karışıklıkları, akciğer probleminden bağımsız olarak görüldüğü ortaya çıktı.
NYU Langone Brooklyn hastanesinde Kovid-19 hastaları ile ilgilenen nörolog Jennifer Frontera, bulguların koronavirüsün beyin ve sinir sistemi üzerindeki etkisi hakkında endişe yarattığını söyledi.
HASTALAR KAFA KARIŞIKLIĞI YAŞIYOR
Fransa'nın Strasbourg kentindeki 58 hastanın incelenmesi üzerine New England Journal of Medicine'de yayınlanan bir makalede ise hastaların yarısından fazlasının kafa karışıklığı yaşadığı ve beyin görüntülerinin iltihaplanmaya işaret ettiği yazıldı.
Kaliforniya Üniversitesi Nöroloji Bölümü Başkanı S Andrew Josephson, "Bunun bir solunum problemi olduğunu duyuyorsunuz, ama aynı zamanda en çok önem verdiğimiz beyni de etkiliyor." açıklamasında bulundu.